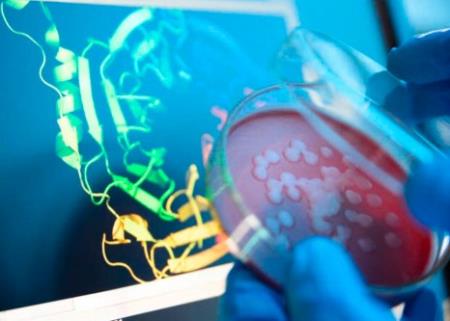
AI tạo ra protein để chống lại ung thư và kháng kháng sinh

Liệu pháp hormone tăng cường tirzepatide, giúp giảm cân đáng kể sau thời kỳ mãn kinh
Phụ nữ sau mãn kinh đang gặp khó khăn trong việc giảm cân có thể tìm thấy một giải pháp hiệu quả bằng cách kết hợp thuốc điều trị tiểu đường tirzepatide với liệu pháp hormone mãn kinh.